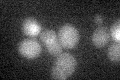
YJL093C
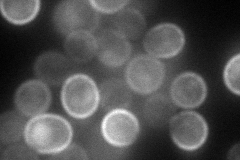
YJL093C
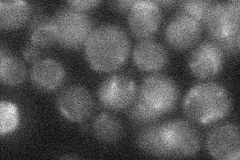
YJL093C
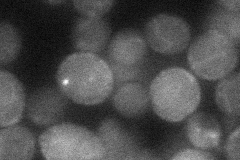
YJL093C

View description
Outward-rectifier potassium channel of the plasma membrane with two pore domains in tandem, each of which forms a functional channel permeable to potassium; carboxy tail functions to prevent inner gate closures; target of K1 toxin
Localization:
Intensity:
Fold change:
Significance:
-
C’ GFP library in SD
below threshold16.66 -
N' NOP1pr-GFP in SD

cell periphery74.1578 -
N' TEF2pr-mCherry in SD
cell periphery,vacuole104.299 -
N' NATIVEpr-GFP in SD
below threshold18.8317 -
N' TEF2pr-VC and Cyto-VN in SD
cell periphery33.534 -
C’ GFP library in SD+DTT

cytosol16.570.99No -
C’ GFP library in SD+H2O2

cytosol15.030.9No -
C’ GFP library in Starvation Media

cytosol17.531.05No -
C’ GFP library on the background of Pup2-DaMP

below threshold -
C’ GFP library on the background of CCT mutant

below threshold15.24370.914244No
